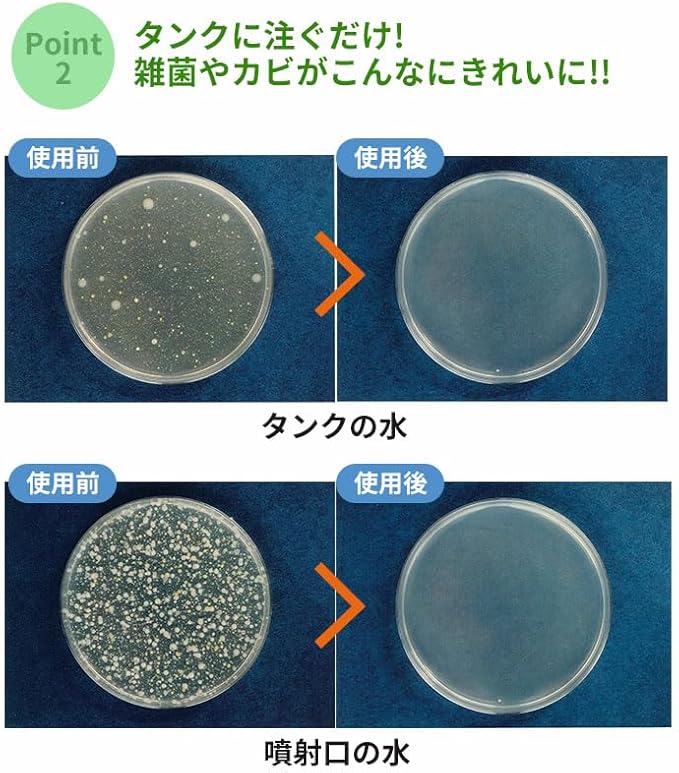

1/6
コジット 加湿器タンクの除菌剤(お徳用) 300ml ユーカリ
¥2,070 税込
残り1点
なら 手数料無料で 月々¥690から
この商品は送料無料です。
限定商品 コジット
商品の形状 液体
商品体積 300 ミリリットル
ユニット数 300.0 ミリリットル
特徴 抗ウイルス性
商品の個数 1
液体内容物を含む はい
HOT コジット(Cogit)
表示を増やす
他バリエーションあり
ご相談ください
サイズ: 300ml
サイズの選択ができます
100ml
商品コード1,052商品コード1,052
在庫あり。
300ml
商品コード1,336商品コード1,336
mlあたり商品コード4(商品コード4商品コード4 / ml)
在庫あり。
スタイル: ユーカリ
スタイルの選択ができます
この商品について
サイズ:幅5.5 奥行5.5 高さ16.5cm
重量:0.3kg
材質:成分/ラベンダーエキス・アザディラクチン(ニームオイル)・大豆エキス・穀物エキス・界面活性剤・水
原産国:日本
※パッケージデザインは予告なく変更する場合があります
商品の説明
加湿器の中の雑菌を除菌。アロマの香りでリラックス。【特長】・加湿器タンクに注ぐだけ! ・除菌成分が大豆アミノ酸とニームエキス天然成分なので、 お子様のいるご家庭でも安心してご使用いただけます。・天然の水溶性アロマオイル配合なのでお好きな香りでリラックス。
-
レビュー
(0)
-
送料・配送方法について
-
お支払い方法について
最近チェックした商品
同じカテゴリの商品
セール中の商品
その他の商品